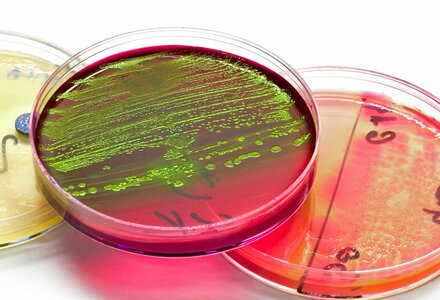
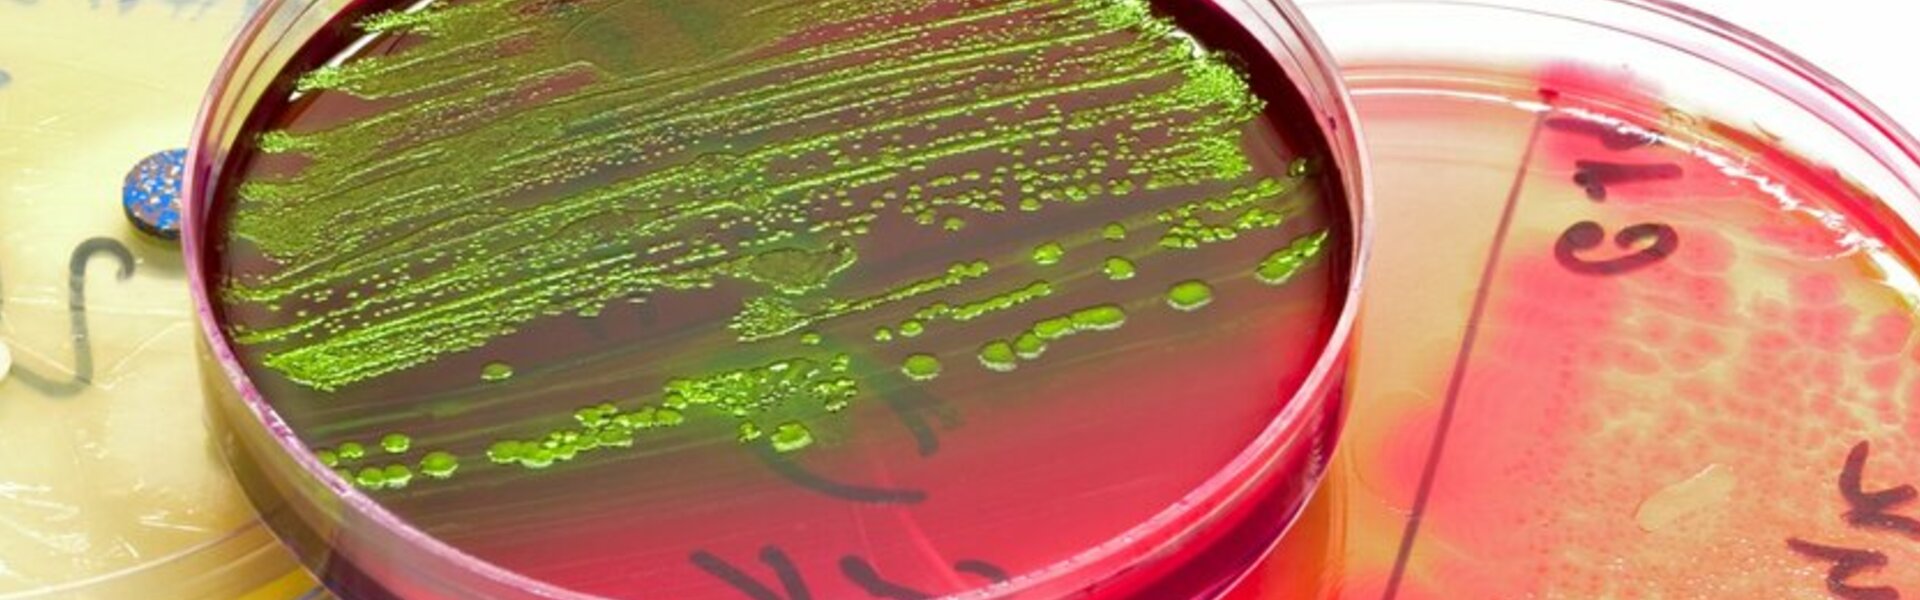

Beat Listeria!
Meet the Eurofins Challenge Team
Uw product écht veilig in de schappen

Dit is Sandra Roesink. Samen met Carien Voogt en Hanna van Gool maakt zij deel uit van ons leading Challenge Team. Haar team prijst niet alleen de manier waarop zij leidinggeeft aan het Challengetestteam: ook haar organisatietalent en haar kennis van ongekoelde presentatieproducten en samengestelde producten vallen op. Zij is een kei in samenwerken en heeft veel ervaring in challengetesting. Mede onder haar supervisie besmetten analisten een staal in het lab opzettelijk met een listeriasoort die goed in het specifieke product kan groeien. Ze dagen het uit te groeien binnen de houdbaarheidstermijn, volgens het bewaaradvies. Zo spoort Roesink, samen met haar collega’s, gevaarlijke situaties op via een hoogstaande onderzoeksmethode, die leidt tot de meest nauwkeurige resultaten. En dat maakt de kant-en-klare voeding die in de schappen ligt, een stuk veiliger.
Gebruikmaken van onze ijzersterke challengetestmethode? Hand over your ‘challenge’: test us! Bel of mail Sandra Roesink via +31 (0) 88 831 03 39 of contractresearch@eurofins.com.
Eurofins Fresh & Safe 2.0
Met Eurofins bent u in staat om de veiligheid en versheid van uw voedsel en water naar het volgende niveau te brengen. Wij noemen dit Fresh & Safe 2.0!
Heeft u een vraag voor ons Challenge Team?
Bel ons
+31 (0) 88 831 03 39